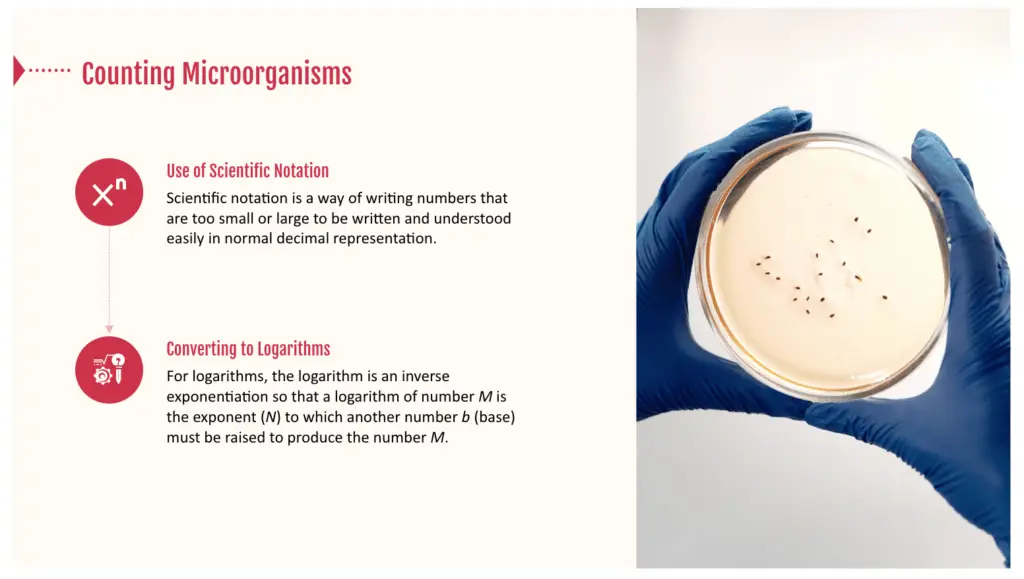
Changes to USDA Meat Temperature Regulations

This course will help you interpret updated USDA guidelines and better understand how to ensure the safety and quality of your RTE meat and poultry products.
The USDA has had regulations in place since 1999 covering lethality and chilling (stabilization) performance standards for certain fully-cooked meat and poultry products. Processors who make these specific products are required to meet these performance standards or develop scientifically-based control measures delivering an equivalent margin of safety.
While not legally required, the agency expects producers of all other meat and poultry products to also follow these standards as part of their HACCP plan. The USDA recently published updated guidelines to address both lethality (Appendix A) and stabilization (Appendix B) controls.
These guidelines were revised in response to changing scientific knowledge, comments from users and academia, and a recognition that some standards are difficult to meet.
This course deciphers the language in the revised appendices, reviews the impacts of these revisions and offers insights on how to address both lethality and stabilization controls to minimize impacts on the producer.

To register for this course, please visit our training portal.

We use cookies to improve your experience on our site. By using our site, you consent to cookies.
Manage your cookie preferences below:
Essential cookies enable basic functions and are necessary for the proper function of the website.
These cookies are needed for adding comments on this website.
Google reCAPTCHA helps protect websites from spam and abuse by verifying user interactions through challenges.
Google Tag Manager simplifies the management of marketing tags on your website without code changes.
Statistics cookies collect information anonymously. This information helps us understand how visitors use our website.
Google Analytics is a powerful tool that tracks and analyzes website traffic for informed marketing decisions.
Service URL: policies.google.com (opens in a new window)
You can find more information in our Privacy Policy and .